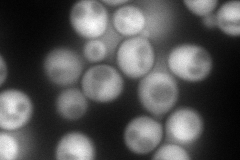
YNL307C
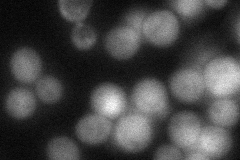
YNL307C
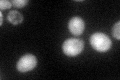
YNL307C

View description
Protein serine/threonine/tyrosine (dual-specificity) kinase involved in control of chromosome segregation and in regulating entry into meiosis; related to mammalian glycogen synthase kinases of the GSK-3 family
Localization:
Intensity:
Fold change:
Significance:
-
C’ GFP library in SD

cytosol73.05 -
N' NOP1pr-GFP in SD
cytosol250.345 -
N' TEF2pr-mCherry in SD

cytosol359.24 -
N' NATIVEpr-GFP in SD
cytosol72.7728 -
N' TEF2pr-VC and Cyto-VN in SD

cytosol72.022 -
C’ GFP library in SD+DTT

cytosol72.910.99No -
C’ GFP library in SD+H2O2

cytosol79.41.08No -
C’ GFP library in Starvation Media
cytosol94.941.29No -
C’ GFP library on the background of Pup2-DaMP

cytosol -
C’ GFP library on the background of CCT mutant

cytosol73.63321.00795No
